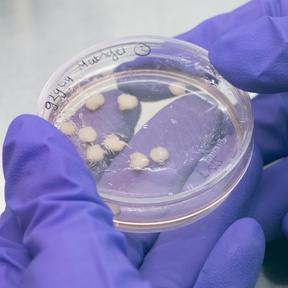
Hersenorganoids

Welkom bij Drijfveren. Hier vertellen onderzoekers wat hen motiveert om proefdiervrije alternatieven te ontwikkelen. Dit keer is het aan Lois Kistemaker PhD-student aan het UMC Utrecht. Lois onderzoekt de barrière tussen het bloed en de hersenen, de zogenoemde bloed-hersenbarrière. Het onderzoek waaraan Lois werkt heet CONNECT, omdat in dit project een bloed-hersenbarrière-op-een-chip wordt verbonden met mini-hersentjes. In dit blog licht Lois toe waarom zij proefdiervrij onderzoek doet.

Bewust gekozen voor opleiding zonder proefdieren
“Vanaf het begin van mijn studie wilde ik niet met proefdieren werken. Gewoon uit persoonlijke redenen, omdat ik het -bij gebrek aan een beter woord- gewoon zielig vind. Ik heb ook nooit proefdierkunde gedaan, of een vak gevolgd met proefdieren. Ook in mijn onderzoeksstages heb ik het werken met proefdieren ontweken, omdat ik daar niet gelukkig van zou worden. Ik hoorde verhalen van collega’s of stagebegeleiders, over hun onderzoek met proefdieren en dat ze het zelf ook helemaal niet leuk vonden om te doen. Dus dat is waarom ik me ben gaan richten op onderzoek met menselijke cellen.”
Hersenonderzoek met muizen werkt soms minder goed
“Vanuit de wetenschappelijke kant vind ik het ook heel belangrijk om mensgericht onderzoek te doen. Want we richten ons nu vooral op muizen in biomedisch onderzoek. Dat we muizenhersenen beter kennen dan mensenhersens, terwijl we onderzoek willen doen naar de menselijke hersen, dat is voor mij gewoon heel dubbel.
En er zijn zoveel hersenaandoeningen, waar al zo lang onderzoek naar gedaan wordt, en waar nog steeds geen oplossing voor is. Een van de redenen daarvoor, is denk ik het gebruik van proefdieren. Ik neem als voorbeeld de hersenziekte Alzheimer. Er is al heel lang een bepaalde theorie over de oorzaak van alzheimer en er worden vaak medicijnen getest op alzheimer-muis-modellen. Die medicijnen werken prima bij muizen en er komen overtuigende resultaten uit de onderzoeken. Maar als die medicijnen daadwerkelijk bij mensen worden getest, dan blijken ze toch tegen te vallen. Dat komt omdat muizen geen alzheimer krijgen, zoals wij dit als mensen krijgen. Muizen moeten daarom bijvoorbeeld genetisch gemodificeerd worden, zodat zij gebruikt kunnen worden voor Alzheimeronderzoek. Daarom is het echt van belang om menselijke onderzoeksmodellen te ontwikkelen.”
“En er zijn zoveel hersenaandoeningen, waar al zo lang onderzoek naar gedaan wordt, en waar nog steeds geen oplossing voor is. Een van de redenen daarvoor, is denk ik het gebruik van proefdieren.”

Knop omschakelen
“We moeten gewoon een knop omschakelen, want al het geld, alle moeite, alle tijd die in onderzoek naar hersenaandoeningen is gestoken, heeft in sommige gevallen niet heel veel opgeleverd. Ik denk dat we echt die omschakeling moeten gaan maken. En alleen dan kunnen we vooruit op heel veel vlakken waar we nu erg tegengehouden worden door het gebruik van proefdieren. Ik denk dat het belangrijk is dat we onderzoekers overtuigen van het feit dat de overstap naar menselijk onderzoek echt heel belangrijk is en ook de moeite waard is.”

Proefdiervrij hersenonderzoek
“In het onderzoek waar ik aan meewerk wordt een model gemaakt om hersenmedicijnen mee te kunnen testen. Voor het ontwikkelen en testen van medicijnen voor hersenziektes, zoals Alzheimer en Parkinson, is één onderdeel van je hersenen heel belangrijk. Namelijk de barrière tussen ons bloed en de hersenen, de zogenoemde bloed-hersenbarrière. Deze barrière is belangrijk, want stoffen die in het bloed zitten en die je liever niet in de hersenen wilt hebben, die worden daardoor tegengehouden. Maar een negatieve kant is dat medicijnen die gebruikt worden bij hersenziektes, vaak ook tegengehouden worden door deze barrière.
In ons onderzoek maken wij een onderzoeksmodel van de bloed-hersenbarrière, zonder hierbij proefdieren te gebruiken. Dus daarvoor gebruiken we een plastic chip. En daarbij maken we ook gebruik van menselijke cellen. En daarnaast kweken wij ook menselijk mini-hersenen (organoids), dit zijn eigenlijk klompjes van menselijke hersencellen. En dit zijn best bijzondere mini-hersenen, omdat ze zich spontaan ontwikkelen en meerdere delen van het brein representeren.
En wat wij vervolgens doen is dat we een verbinding maken tussen de bloed-hersenbarrière-op-een-chip en de hersenorganoids. Dit proberen wij zo goed mogelijk na te bootsen, zoals dat is in de echte menselijke hersenen. En daarbij kijken we vervolgens of die twee in connectie gaan met elkaar. Wij kijken naar de interacties tussen cellen. Dit is niet eerder uitgevoerd in onderzoek, op deze manier. En wij hopen dat met dit model, in de toekomst, medicijnen voor hersenziekten getest kunnen worden. Hopelijk kunnen we daarmee het testen van medicijnen op muizen verminderen, en tegelijk relevantere menselijke modellen maken.”
Dit onderzoeksproject is medegefinancierd door de Vereniging Samenwerkende Gezondheidsfondsen (SGF), NWO en ZonMW met PPS toeslag beschikbaar gesteld door Topsector Life Science & Health (Health~Holland), als onderdeel van het gezamenlijke onderzoeksprogramma Humane Meetmodellen.
Lois inspireert ons, en wat nog belangrijker is, zij inspireert anderen. Zij bewijst dat proefdiervrije wetenschap de toekomst heeft. Bedankt Lois, dat je de tijd hebt genomen om onze vragen te beantwoorden! We wensen je het allerbeste met je prachtige werk en samen kunnen we onze impact vergroten naar een wereld zonder dierproeven.




